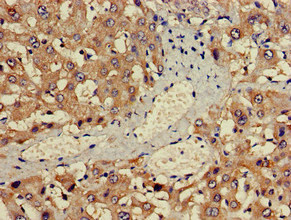

ALAS1 Antibody
-
中文名稱:ALAS1兔多克隆抗體
-
貨號:CSB-PA001559LA01HU
-
規(guī)格:¥440
-
圖片:
-
其他:
產(chǎn)品詳情
-
產(chǎn)品名稱:Rabbit anti-Homo sapiens (Human) ALAS1 Polyclonal antibody
-
Uniprot No.:
-
基因名:ALAS1
-
別名:5 aminolevulinate synthase antibody; 5 aminolevulinate synthase nonspecific mitochondrial antibody; 5 aminolevulinic acid synthase antibody; 5-aminolevulinate synthase antibody; 5-aminolevulinic acid synthase 1 antibody; Alas 1 antibody; ALAS 3 antibody; ALAS antibody; ALAS H antibody; ALAS HOUSEKEEPING TYPE antibody; ALAS N antibody; ALAS-H antibody; alaS1 antibody; ALAS3 antibody; ALASH antibody; Aminolevulinate delta synthase 1 antibody; Aminolevulinic acid synthase 1 antibody; Delta ALA synthetase antibody; Delta aminolevulinate synthase antibody; Delta-ALA synthase 1 antibody; Delta-aminolevulinate synthase 1 antibody; HEM1_HUMAN antibody; MIG 4 antibody; MIG4 antibody; Migration inducing protein 4 antibody; mitochondrial antibody; nonspecific antibody
-
宿主:Rabbit
-
反應(yīng)種屬:Human
-
免疫原:Recombinant Human 5-aminolevulinate synthase, nonspecific, mitochondrial protein (57-285AA)
-
免疫原種屬:Homo sapiens (Human)
-
標(biāo)記方式:Non-conjugated
本頁面中的產(chǎn)品,ALAS1 Antibody (CSB-PA001559LA01HU),的標(biāo)記方式是Non-conjugated。對于ALAS1 Antibody,我們還提供其他標(biāo)記。見下表:
-
克隆類型:Polyclonal
-
抗體亞型:IgG
-
純化方式:>95%, Protein G purified
-
濃度:It differs from different batches. Please contact us to confirm it.
-
保存緩沖液:Preservative: 0.03% Proclin 300
Constituents: 50% Glycerol, 0.01M PBS, pH 7.4 -
產(chǎn)品提供形式:Liquid
-
應(yīng)用范圍:ELISA, IHC
-
推薦稀釋比:
Application Recommended Dilution IHC 1:20-1:200 -
Protocols:
-
儲存條件:Upon receipt, store at -20°C or -80°C. Avoid repeated freeze.
-
貨期:Basically, we can dispatch the products out in 1-3 working days after receiving your orders. Delivery time maybe differs from different purchasing way or location, please kindly consult your local distributors for specific delivery time.
-
用途:For Research Use Only. Not for use in diagnostic or therapeutic procedures.
相關(guān)產(chǎn)品
靶點詳情
-
基因功能參考文獻(xiàn):
- The mutation in CLPX inactivates its ATPase activity, resulting in coassembly of mutant and WT protomers to form an enzyme with reduced activity. The presence of low-activity CLPX increases the posttranslational stability of ALAS, causing increased ALAS protein and ALA levels, leading to abnormal accumulation of PPIX. PMID: 28874591
- the heme-binding site in the N-terminal region of the mature ALAS1 protein is also necessary for the heme-dependent oxidation of ALAS1. PMID: 27496948
- ALAS1 mRNA and activity were elevated approximately ~3- and 5-fold, and HMB synthase activity was approximately half-normal (~42%) PMID: 26062020
- The -853T variant functions as an enhancer in the presence of estrogen and speculates that the -1253A variant reduces transcription activity. PMID: 19656447
- These results indicate that ALAS1 is a novel NR5A-target gene and participates in steroid hormone production. PMID: 23024262
- Lon peptidase 1 (LONP1)-dependent breakdown of mitochondrial 5-aminolevulinic acid synthase protein by heme in human liver cells. PMID: 21659532
- REVIEW:active site and mechanistic analysis, protein folding, structure and function. PMID: 11929042
- REVIEW: mechanisms involving ALAS deficiency, point mutations, post translational processing, and complex formation with succinyl CoA synthetase subunit B in the pathogenesis of hereditary sideroblastic anemia. PMID: 11929048
- ALAS expression is regulated by AP-1 complex through sequestration of cAMP-response element protein (CRE)-binding protein (CBP) coactivator in human cells PMID: 12433930
- ALAS gene expression is regulated by Hepatic nuclear factor 3 and nuclear factor 1 PMID: 15123725
- First described frameshift ALAS2 mutation, CD506-507 (-C). PMID: 15477213
- in the liver of Acute liver failure patients, there may be an increase in free heme concentration which down-regulating ALAS1 gene expression PMID: 15547665
- Alternative splicing of human ALAS1 generates two mRNAs with different 5'-UTRs: a major one, where exon 1B is omitted, and a minor form containing exon 1B. PMID: 15710391
- 5-aminolevulinate synthase gene repression by the potent tumor promoter, TPA, involves multiple signal transduction pathways PMID: 15797241
- Expression of candidate genes HPRT1 and ALAS1 in malignant and non-malignant prostate tissue samples after microdissection. PMID: 17628775
- Differential regulation of human ALAS1 mRNA and protein levels by heme and cobalt protoporphyrin. PMID: 18719978
- In this study, we show significant reductions of the rate-limiting enzymes involved in heme biosynthesis, ALAS1 in the postmortem cortex of Alzheimer's disease subjects, providing additional evidence of abnormal heme homeostasis in Alzheimer's disease. PMID: 19477221
顯示更多
收起更多
-
亞細(xì)胞定位:Mitochondrion matrix.
-
蛋白家族:Class-II pyridoxal-phosphate-dependent aminotransferase family
-
數(shù)據(jù)庫鏈接:
Most popular with customers
-
-
YWHAB Recombinant Monoclonal Antibody
Applications: ELISA, WB, IHC, IF, FC
Species Reactivity: Human, Mouse, Rat
-
Phospho-YAP1 (S127) Recombinant Monoclonal Antibody
Applications: ELISA, WB, IHC
Species Reactivity: Human
-
-
-
-
-